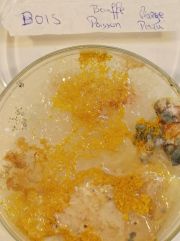
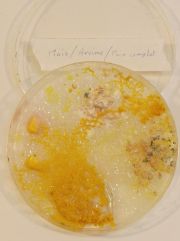
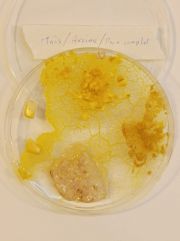

Téléversements par Paddy
Aller à la navigation
Aller à la recherche
Cette page spéciale permet de lister tous les fichiers importés.
| Date | Nom | Vignette | Taille | Description | Versions |
|---|---|---|---|---|---|
| 17 novembre 2025 à 16:59 | PhotonMonoX6K 1.webp (fichier) | Erreur lors de la création de la vignette : Unable to run external programs, proc_open() is disabled.
Error code: 1 |
42 Kio | 1 | |
| 12 mars 2025 à 14:59 | LampeLedOnlfait pcb.png (fichier) |  |
43 Kio | 1 | |
| 12 mars 2025 à 13:08 | Soudure tuto.png (fichier) |  |
488 Kio | 1 | |
| 12 mars 2025 à 13:05 | Ledwiring-3594285797.jpg (fichier) |  |
82 Kio | 1 | |
| 12 mars 2025 à 13:02 | LampeLedOnlfait.png (fichier) |  |
75 Kio | 1 | |
| 8 janvier 2025 à 11:25 | Reparation.pdf (fichier) | 14,66 Mio | 1 | ||
| 24 septembre 2024 à 16:48 | Pref inkscape dimensions sans contour selection.png (fichier) | 6 Kio | 1 | ||
| 24 septembre 2024 à 16:46 | Pref inkscape dimensions sans contour.png (fichier) |  |
12 Kio | 1 | |
| 13 avril 2024 à 10:02 | Imager.png (fichier) |  |
37 Kio | 1 | |
| 1 mars 2024 à 15:59 | Water-Flow-Sensor-ESP8266-640x330.jpg (fichier) |  |
29 Kio | 1 | |
| 27 janvier 2024 à 16:51 | RainbowLedStick.jpg (fichier) |  |
32 Kio | 1 | |
| 27 janvier 2024 à 16:49 | Ombrecolorees.jpg (fichier) |  |
2,66 Mio | 1 | |
| 22 mars 2023 à 17:31 | Marque Plante.jpg (fichier) |  |
875 Kio | 1 | |
| 22 mars 2023 à 17:24 | Clipplante.png (fichier) |  |
346 Kio | 1 | |
| 20 janvier 2023 à 14:30 | Stylo.png (fichier) |  |
13 Kio | 1 | |
| 20 janvier 2023 à 14:26 | Contenant.png (fichier) |  |
20 Kio | 1 | |
| 20 janvier 2023 à 14:15 | Moteur.png (fichier) |  |
16 Kio | 1 | |
| 20 janvier 2023 à 14:14 | Moteur désaxé.png (fichier) |  |
19 Kio | 1 | |
| 17 janvier 2023 à 17:17 | Gribouilleur.png (fichier) |  |
74 Kio | 1 | |
| 18 août 2022 à 10:34 | SDG list.png (fichier) |  |
243 Kio | 1 | |
| 31 mars 2022 à 09:54 | Microscope blob10.png (fichier) |  |
460 Kio | 1 | |
| 31 mars 2022 à 09:53 | Microscope blob9.png (fichier) |  |
611 Kio | 1 | |
| 31 mars 2022 à 09:52 | Microscope blob8.png (fichier) |  |
553 Kio | 1 | |
| 31 mars 2022 à 09:51 | Microscope blob7.png (fichier) |  |
572 Kio | 1 | |
| 31 mars 2022 à 09:51 | Microscope blob6.png (fichier) |  |
556 Kio | 1 | |
| 31 mars 2022 à 09:50 | Microscope blob4.png (fichier) |  |
614 Kio | 1 | |
| 31 mars 2022 à 09:45 | Microscope blob5.png (fichier) |  |
579 Kio | 1 | |
| 31 mars 2022 à 09:44 | Microscope blob3.png (fichier) |  |
600 Kio | 1 | |
| 31 mars 2022 à 09:43 | Microscope blob2.png (fichier) |  |
555 Kio | 1 | |
| 31 mars 2022 à 09:42 | Microscope blob1.png (fichier) |  |
491 Kio | 1 | |
| 30 mars 2022 à 16:43 | PacBlob6j.jpg (fichier) |  |
1,74 Mio | 1 | |
| 30 mars 2022 à 16:42 | Repas5 6j.jpg (fichier) | |
1,88 Mio | 1 | |
| 30 mars 2022 à 16:41 | Repas4 6j.jpg (fichier) |  |
1,65 Mio | 1 | |
| 30 mars 2022 à 16:40 | Repas3 6j.jpg (fichier) | |
1,68 Mio | 1 | |
| 30 mars 2022 à 16:38 | Repas2 6j.jpg (fichier) |  |
1,67 Mio | 1 | |
| 30 mars 2022 à 16:37 | Repas1 6j.jpg (fichier) |  |
1,59 Mio | 1 | |
| 25 mars 2022 à 15:33 | PacBlob22h.jpg (fichier) |  |
1,61 Mio | 1 | |
| 25 mars 2022 à 15:28 | Repas5 22h.jpg (fichier) |  |
1,96 Mio | 1 | |
| 25 mars 2022 à 15:27 | Repas4 22h.jpg (fichier) |  |
1,72 Mio | 1 | |
| 25 mars 2022 à 15:26 | Repas3 22h.jpg (fichier) | |
1,68 Mio | 1 | |
| 25 mars 2022 à 15:23 | Repas2 22h.jpg (fichier) |  |
1,72 Mio | 1 | |
| 25 mars 2022 à 15:20 | Repas1 22h.jpg (fichier) |  |
1,62 Mio | 1 | |
| 24 mars 2022 à 18:47 | Repas 5.jpg (fichier) |  |
1,91 Mio | 1 | |
| 24 mars 2022 à 18:45 | Repas 4.jpg (fichier) |  |
1,55 Mio | 1 | |
| 24 mars 2022 à 18:44 | Repas 3.jpg (fichier) |  |
1,6 Mio | 1 | |
| 24 mars 2022 à 18:42 | Repas 2.jpg (fichier) |  |
1,66 Mio | 1 | |
| 24 mars 2022 à 18:41 | Repas1.jpg (fichier) |  |
1,66 Mio | 1 | |
| 24 mars 2022 à 18:36 | PacBlobZoom.jpg (fichier) |  |
1,46 Mio | 1 | |
| 24 mars 2022 à 18:35 | PacBlob.jpg (fichier) |  |
1,98 Mio | 1 | |
| 10 février 2022 à 18:20 | Meshlab logo.png (fichier) |  |
11 Kio | 1 |